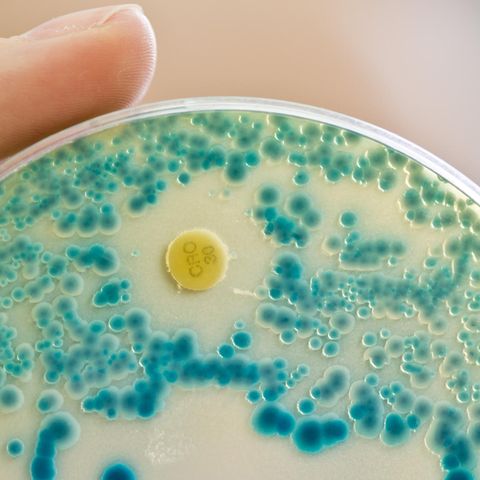

Gut versteckt auf der Webseite des Landwirtschaftsministeriums steht eine brisante Datensammlung. Sie zeigt, wie häufig Nutztiere mit Antibiotika behandelt werden.
Nun liegen die aktuellen Zahlen für das zweite Halbjahr 2018 vor. Zuerst die gute Nachricht: Bei der Mast von Schweinen, Rindern und Kälbern werden weniger Antibiotika verwendet als in den letzten Jahren.
Alarmierend sieht es dagegen bei den Masthühnern aus: Dort ist der Anstieg dramatisch. Seit Anfang 2016 steigt der Wert rasend schnell. Von 11.860 auf den aktuellen Wert von 19.745.
Die Statistik ist nicht einfach zu lesen. Sie verrät nicht wie viel Antibiotika eingesetzt werden. Sie zeigt aber, wie häufig das Medikament verwendet wird: die sogenannte Therapiehäufigkeit. Dieser Wert errechnet sich so: Anzahl behandelter Tiere wird multipliziert mit der Anzahl der Behandlungstage und geteilt durch die durchschnittliche Anzahl gehaltener Tiere pro Halbjahr.
Zu kompliziert? Man kann auch sagen: Je höher die Werte, desto intensiver greifen die Mäster in die Antibiotika-Apotheken. In der Tiermast werden jedes Jahr hunderte Tonnen Antibiotika verbraucht. In Deutschland waren es 2017 rund 733 Tonnen.
Auch Experten im Landwirtschaftsministerium von Julia Klöckner (CDU) sind durch die hohen Antibiotika-Werte bei Masthühnern aufgeschreckt. Eine Sprecherin formulierte es gegenüber dem stern diplomatisch. "Das ist nicht zufriedenstellend." Woran es liegt, dass in deutschen Hühnerställen so viele Antibiotika eingesetzt werden, wisse man nicht. Das Ziel sei es, die Mengen zu reduzieren.
Antibiotika sind das wichtigste Instrument zur Behandlung von bakteriellen Infektionskrankheiten bei Tieren und bei Menschen. Jedoch nehmen die Fälle von Antibiotika-Resistenzen zu – auch in Deutschland. Dadurch können Medikamente ihre Wirkung verlieren und Menschen sterben. In den USA gab es bereits Infektionen mit Superkeimen, gegen die kein Antibiotikum mehr hilft.
Multiresistente Keime - tausende Todesfälle jährlich
Die Europäische Seuchenbehörde ECDC hat dazu Zahlen aus dem Jahr 2015 veröffentlicht: In Europa starben in diesem Jahr über 33.000 Menschen an Infektionen mit multiresistenten Keimen. Demzufolge würden jährlich genauso viele Menschen an diesen Infektionen sterben wie an Influenza, Tuberkulose und HIV/Aids zusammen.
In Deutschland starben 2300 Menschen an einer Infektion mit multiresistenten Keimen, besonders betroffen: Kinder unter einem Jahr und Ältere über 65 Jahren.
Auch beim Zentralverband der Deutschen Geflügelwirtschaft (ZDG) sind die Fachleute aufgeschreckt. Eine Sprecherin versucht, die hohen Werte aus den Hühnerställen zu erklären. Man gebe sich große Mühe, in den Hühnerställen den Einsatz von "Reserveantibiotika" zu reduzieren.
"Reserveantibiotika" sollen für den Einsatz in der Humanmedizin "reserviert" bleiben. Die Geflügel-Lobby argumentiert: Bei diesen Medikamenten, habe man in der Hühnermast in den letzten Jahren einen signifikanten Rückgang erzielt. 2014 waren es noch rund 68 Tonnen, 2017 rund 59 Tonnen. Heißt im Klartext: Es ist weniger, aber immer noch zu viel. Denn insgesamt steigen die Werte in der Hühnermast.
Auch dazu liefern die Hühnermäster einen Erklärungsversuch: Um die "Reserveantibiotika"zu schonen werden in den Hühnerställen nun vermehrt "Zwei-Wirkstoff-Präparate" angewendet. Statt eines einzelnen Wirkstoffes erfasse die Statistik nun zwei Werkstoffe für ein- und denselben Anwendungsvorgang. Das sei der Grund, warum die Werte in der Statistik des Landwirtschaftsministeriums so deutlich steigen.
Bei den Puten sieht es besser aus
Doch eine Frage bleibt offen: Warum gelingt den Hühnerställen nicht, was bei den Puten schon länger funktioniert? Denn bei den Puten sind die Werte in der Antibiotika-Statistik besser.
Das liegt daran, dass die Mäster in den vergangenen Jahren das Haltungsmanagement in den Ställen verändert haben. So werden zum Beispiel die jungen Puten (vom Kükenalter bis zur fünften Lebenswoche) von den älteren Masttieren räumlich getrennt. "Pingpong-Effekte", die gegenseitige und andauernde Ansteckung mit Krankheitskeimen, werden minimiert. Weniger Antibiotika müssen eingesetzt werden.
Warum also, wird das nicht längst auch so in den Hühnerställen gemacht?
Bereits vorab wurde vom Bundesamt für Verbraucherschutz und Lebensmittelsicherheit (BVL) jedem Mäster die Kennzahl der Therapiehäufigkeit für seinen Betrieb mitgeteilt. Liegt er darüber, muss der Landwirt gemeinsam mit seinem Tierarzt die Gründe für den hohen Verbrauch ermitteln und Möglichkeiten zur Reduzierung prüfen.